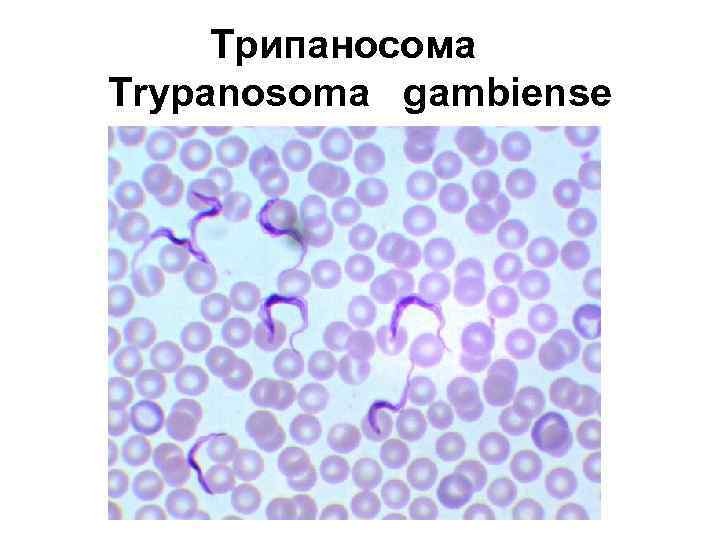

Тип Простейшие (PROTOZOA) Класс Саркодовые (SARCODINA) Класс Жгутиковые (FLAGELLATA)
Тип Простейшие (PROTOZOA) Класс Саркодовые (SARCODINA) Класс Жгутиковые (FLAGELLATA)
 План лекции 1) 2) 3) 4) 5) Общая характеристика типа Простейшие. Общая характеристика класса Саркодовые. Морфология, циклы развития, пути заражения человека паразитическими саркодовыми. Методы лабораторной диагностики, профилактика этих заболеваний. 0 бщая характеристика класса Жгутиковые Морфология, циклы развития, пути заражения человека паразитическими жгутиконосцами. Методы лабораторной диагностики, профилактика этих заболеваний.
План лекции 1) 2) 3) 4) 5) Общая характеристика типа Простейшие. Общая характеристика класса Саркодовые. Морфология, циклы развития, пути заражения человека паразитическими саркодовыми. Методы лабораторной диагностики, профилактика этих заболеваний. 0 бщая характеристика класса Жгутиковые Морфология, циклы развития, пути заражения человека паразитическими жгутиконосцами. Методы лабораторной диагностики, профилактика этих заболеваний.
 ИМПЕРИЯ КЛЕТОЧНЫЕ CELLULATA НАДЦАРСТВО ЭУКАРИОТЫ EUCARYOTA ЦАРСТВО ЖИВОТНЫЕ ZOA ПОДЦАРСТВО ОДНОКЛЕТОЧНЫЕ MONOCYTOZOA ТИП ПРОСТЕЙШИЕ PROTOZOA
ИМПЕРИЯ КЛЕТОЧНЫЕ CELLULATA НАДЦАРСТВО ЭУКАРИОТЫ EUCARYOTA ЦАРСТВО ЖИВОТНЫЕ ZOA ПОДЦАРСТВО ОДНОКЛЕТОЧНЫЕ MONOCYTOZOA ТИП ПРОСТЕЙШИЕ PROTOZOA
 ТИП ПРОСТЕЙШИЕ PROTOZOA • • Класс Саркодовые Sarcodina Класс Жгутиковые Flagellata Класс Споровики Sporozoa Класс Инфузории Infusoria
ТИП ПРОСТЕЙШИЕ PROTOZOA • • Класс Саркодовые Sarcodina Класс Жгутиковые Flagellata Класс Споровики Sporozoa Класс Инфузории Infusoria
 Класс Саркодовые Sarcodina • Entamoeba histolytica • Entamoeba coli • Entamoeba gingivalis
Класс Саркодовые Sarcodina • Entamoeba histolytica • Entamoeba coli • Entamoeba gingivalis
 Класс Жгутиковые Flagellata • • • Trypanosoma gambiense Leishmania tropica major Leishmania tropica minor Leishmania donovani Leishmania infantum Trichomonas hominis Trichomonas vaginalis Trichomonas tenax Lamblia intestinalis
Класс Жгутиковые Flagellata • • • Trypanosoma gambiense Leishmania tropica major Leishmania tropica minor Leishmania donovani Leishmania infantum Trichomonas hominis Trichomonas vaginalis Trichomonas tenax Lamblia intestinalis
 Класс Споровики Sporozoa • • • Toxoplasma gondii Plasmodium vivax Plasmodium falciparum Plasmodium ovale Plasmodium malariae
Класс Споровики Sporozoa • • • Toxoplasma gondii Plasmodium vivax Plasmodium falciparum Plasmodium ovale Plasmodium malariae
 Класс Инфузории Infusoria • Balantidium coli
Класс Инфузории Infusoria • Balantidium coli
 Амёбы. Слева направо: амёба-протей, дизентерийная амёба, эвглифа, арцелла, панцирная амёба диффлюгия
Амёбы. Слева направо: амёба-протей, дизентерийная амёба, эвглифа, арцелла, панцирная амёба диффлюгия
 Крупная вегетативная форма дизентерийной амебы Entamoeba histolytica
Крупная вегетативная форма дизентерийной амебы Entamoeba histolytica
 Класс Жгутиковые Flagellata • • • Trypanosoma gambiense Leishmania tropica major Leishmania tropica minor Leishmania donovani Leishmania infantum Trichomonas hominis Trichomonas vaginalis Trichomonas tenax Lamblia intestinalis
Класс Жгутиковые Flagellata • • • Trypanosoma gambiense Leishmania tropica major Leishmania tropica minor Leishmania donovani Leishmania infantum Trichomonas hominis Trichomonas vaginalis Trichomonas tenax Lamblia intestinalis
 Лямблия Lamblia intestinalis
Лямблия Lamblia intestinalis
 Трихомонада урогенитальная Trichomonas vaginalis
Трихомонада урогенитальная Trichomonas vaginalis
Трипаносома Trypanosoma gambiense
Трипаносома Trypanosoma gambiense
 Трипаносома Trypanosoma gambiense
Трипаносома Trypanosoma gambiense
 Лейшмании • • Leishmania tropica major Leishmania tropica minor Leishmania donovani Leishmania infantum
Лейшмании • • Leishmania tropica major Leishmania tropica minor Leishmania donovani Leishmania infantum